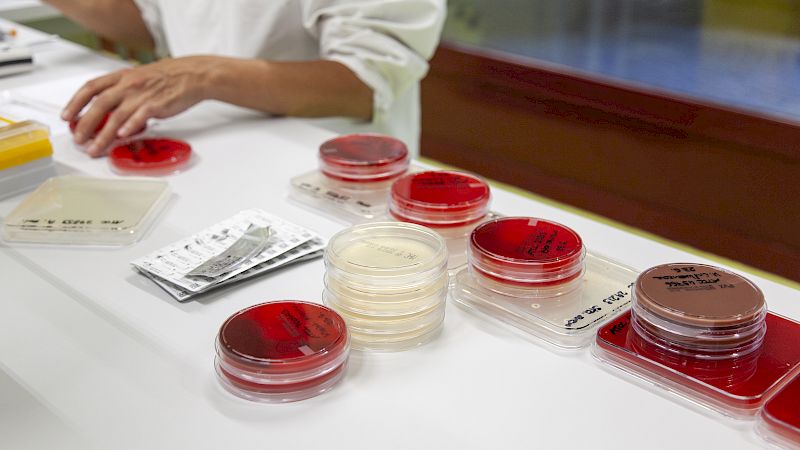

Präanalytik
Näher. Näher dran.
E-Mail info@laboratoiresalamin.ch
Fax +41 (0)27 451 24 56
Siders
Avenue du Rothorn 10
CH-3960 Siders
Tél. +41 (0)27 451 24 51
Öffnungszeiten
Montag bis Freitag :
08:00 bis 12:00
14:00 bis 18:00
Samstag :
08:00 bis 12:00
Sonntag :
geschlossen
Sitten
Avenue du Tourbillon 30
CH-1950 Sitten
Tél. +41 (0)27 322 77 55
Öffnungszeiten
Montag bis Freitag :
08:00 bis 11:30
Nachmittag : nur mit Termin
Collombey
Chemin du Verger 5A
CH-1868 Collombey
Tel. +41 (0)24 472 10 52
Öffnungszeiten
Montag bis Freitag :
08:00 bis 16:30
mit Termin
Brig
Bahnhofapotheke
Bahnhofplatz 1
CH-3900 Brig
Tél. +41 (0)27 924 30 00
Montag bis Freitag :
09:00 bis 10:00
ausserhalb dieser Zeiten :
nur mit Termin
Öffnungszeiten:
Ausserhalb der regulären Öffnungszeiten unserer Standorte steht Ihnen der Bereitschaftsdienst unter folgender Nummer rund um die Uhr zur Verfügung +41 (0)27 451 24 51.